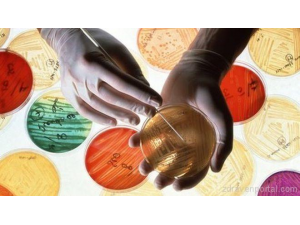
Ген прави бактериите устойчиви на най-мощния антибиотик

Zdravenportal.com
най-функционалният и посещаван сайт за здравеопазване в България
Най-големият Здравен портал в България, предоставящ информация за всички новини, новости и иновации в сферата на здравеопазването, медицината и подържането на здрав дух и здраво тяло. Свързващ Ви с най-добрите доктори, лечебни заведения и ветеринарни клиники. Предоставящ Ви възможността за онлайн запазване на часове. Zdravenportal.com съчетава в себе си качество и дизайн, преплетени с максимално удобство и улеснено меню за потребители търсещи, бърза и удобна връзка за здравни услуги, съвети и специалистите и заведенията, които ги предлагат.

Copyright ©2015 - 2025 www.zdravenportal.com by WebSolution Ltd.